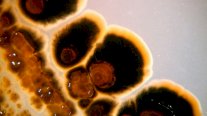
الأطباء يخشون موجة سرطانات نادرة

جنيف: لا يزال كوفيد-19 يودي بنحو 1700 شخص أسبوعيا في أنحاء العالم، حسبما أعلنت منظمة الصحة العالمية، الخميس، داعية الأشخاص الأكثر عرضة لخطر الإصابة لمواصلة تلقي اللقاح ضد الفيروس.
ونبه المدير العام لمنظمة الصحة العالمية، تيدروس أدهانوم غيبريسوس، إلى خطورة تراجع الحماية عبر اللقاحات.
وقال في مؤتمر صحفي إنه رغم استمرار تسجيل وفيات، فإن "البيانات تظهر أن الحماية عبر اللقاحات تراجعت بين العاملين في مجال الصحة والأشخاص الذين تزيد أعمارهم عن 60 عاما، وهما من أكثر الفئات عرضة لخطر الإصابة".
وأضاف "توصي منظمة الصحة العالمية بأن يتلقى الأشخاص من الفئات الأكثر عرضة لخطر الإصابة لقاحات مضادة لكوفيد-19 في غضون 12 شهرا من آخر جرعة لهم".
وأُبلغت منظمة الصحة العالمية عن أكثر من سبعة ملايين وفاة بسبب فيروس كورونا، وإن كان يُعتقد أن الحصيلة الحقيقية للجائحة أعلى بكثير.
كما أدى كوفيد-19 إلى ضعف اقتصادي في كثير من الدول وشل الأنظمة الصحية.
وأعلن تيدروس نهاية كوفيد-19 كحالة طوارئ صحية عالمية في أيار (مايو) 2023 بعد أكثر من ثلاث سنوات من رصد الفيروس لأول مرة في ووهان بالصين أواخر 2019.
وحثت منظمة الصحة العالمية الحكومات على مواصلة رصد الفيروسات وتحديد تسلسلها، وضمان الوصول إلى اختبارات وعلاجات ولقاحات موثوقة وبأسعار معقولة.

التعليقات